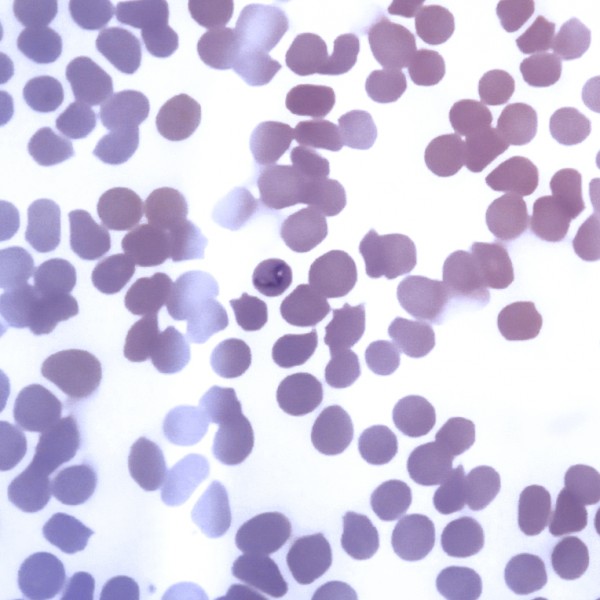

SC
susCaballos
Aprendiendo de Caballos | Ene 29, 2018
Un Negocio Que Galopa
Articulo de Interés leer

SC
susCaballos
Aprendiendo de Caballos | Ene 18, 2018
Conozca Sobre La Leptospirosis equina
Una enfermedad infectocontagiosa leer

SC
susCaballos
Aprendiendo de Caballos | Ene 11, 2018
Todo Lo Que Debe Saber Sobre La Influenza Equina
Un tema de interés leer

SC
susCaballos
Aprendiendo de Caballos | Ene 05, 2018
Piroplasmosis equina, Transmitida por Garrapatas
Articulo de Interes leer

SC
susCaballos
Aprendiendo de Caballos | Dic 21, 2017
Nutrición Y Temperamento
Articulo de interés leer

SC
susCaballos
Aprendiendo de Caballos | Dic 19, 2017

SC
susCaballos
Aprendiendo de Caballos | Nov 23, 2017
CIANDCO Diplomado en Equinotecnia
Matriculate Ya!! leer

SC
susCaballos
Aprendiendo de Caballos | Nov 22, 2017
Piensa Como Tu Caballo y entenderás mejor su mundo
Cinco puntos de Observación leer

SC
susCaballos
Aprendiendo de Caballos | Nov 03, 2017

SC
susCaballos
Aprendiendo de Caballos | Oct 24, 2017
Cuatro Formas De Tomar El Pulso A Tu Caballo
Un Tema de Interes leer

Lo más visto
Noticias Generales
BUSCO PAJILLA BRIBÓN DE SAN ISIDRO FC
MEZCAL | Nov 28, 2025
Noticias Generales
Contruccion de pesebreras Antioquia
Petete90 | Nov 26, 2025
Noticias Generales
Busco caballo isabelo o de crines blancas troton o trochador BUENO
Petete90 | Oct 03, 2025
Noticias Generales
Calendario exposición equina grado A en Boyacá
Chiri | Ago 26, 2025
Noticias Generales
Feria Equina de Palmira 2025
Alfonso Crespo | Ago 09, 2025
Lo más comentado
Noticias Generales
Feria de las flores
Venena | Ago 04, 2019
De feria en feria
JAQUIMONES
JAQUIMON | Dic 10, 2019
Noticias Generales
Donde puedo ver la trasmisión
Rolo | Ago 04, 2019
Noticias Generales
buenos dias , en que página encuentro el arbol genealógico de las yeguas. Gracias
Manoyanqui | Jul 15, 2025
Noticias Generales
Incursionando en el mundo caballista
Yani | Ago 13, 2024